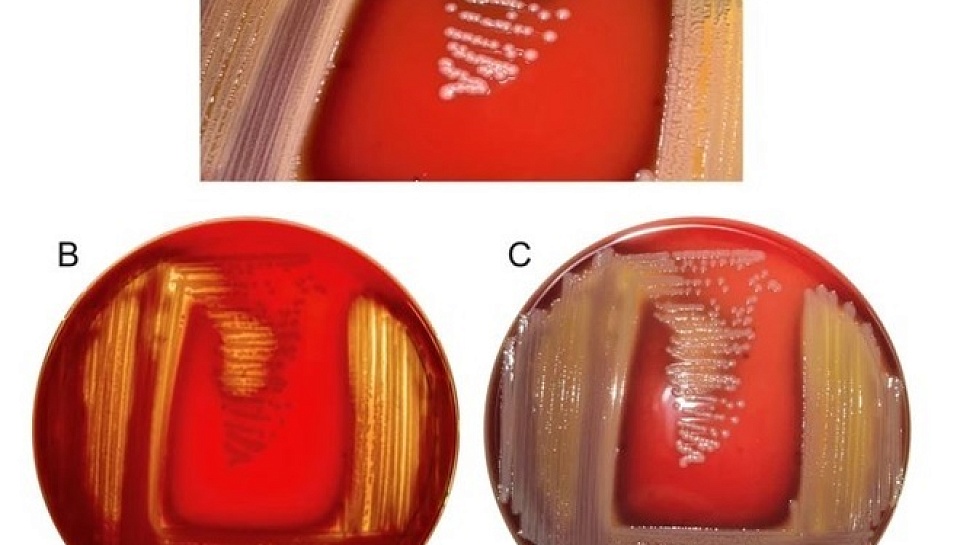

Large-scale genomic analysis of Elizabethkingia anophelis
Недавнее выявление Elizabethkingia anophelis в качестве патогена человека вызывает значительную обеспокоенность в области глобального здравоохранения. Этот микроорганизм способен вызывать тяжелые инфекции и обладает врожденной устойчивостью к антимикробным препаратам. Возможность масштабных вспышек и быстрого распространения подчеркивает важность глубокого понимания биологии и механизмов передачи данного инфекционного агента. В рамках исследования был проведен обширный анализ 540 доступных штаммов E. anophelis, включая новый штамм, выделенный из сырого молока и секвенированный в ходе данного исследования. Анализ пангенома выявил у этого вида открытый и разнообразный пангеном, что свидетельствует о высокой адаптивности и способности выживать в различных условиях. Филогенетический анализ показал сложную популяционную структуру с ограниченной корреляцией между исходными линиями. Были выявлены различные факторы устойчивости к антимикробным препаратам, включая основные и дополнительные, часто связанные с мобильными генетическими элементами в пределах конкретных линий. Анализ мобиломов продемонстрировал динамичный ландшафт, включающий генетические острова, интегративные и конъюгативные элементы, профаговые элементы и небольшое количество плазмид, что подчеркивает сложность механизма горизонтального переноса генов. Исследование акцентирует внимание на адаптивности E. anophelis, характеризующейся широким спектром генов устойчивости к антимикробным препаратам, предполагаемыми факторами вирулентности и генами, повышающими жизнеспособность. Эта адаптивность также обусловлена способностью организма приобретать генетический материал через горизонтальный перенос генов, чему способствуют мобильные генетические элементы, такие как интегративные и конъюгативные элементы (ICE). Потенциал быстрой эволюции данного патогена представляет серьезную проблему для общественного здравоохранения.